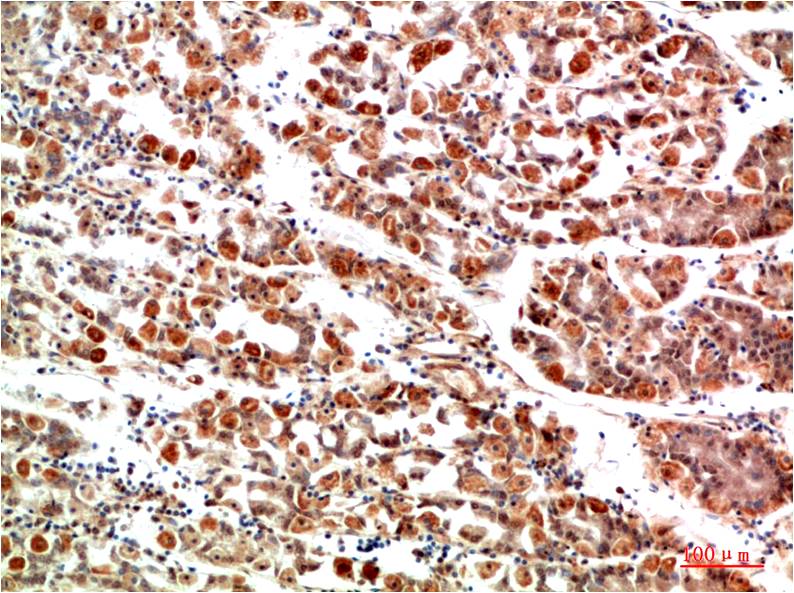

產(chǎn)品中心


Overview
-
 Immunohistochemical analysis of paraffin-embedded Rat Kidney Tissue using IkBα(EA339)Rabbit?pAb diluted at 1:200.
Immunohistochemical analysis of paraffin-embedded Rat Kidney Tissue using IkBα(EA339)Rabbit?pAb diluted at 1:200. -
Immunohistochemical analysis of paraffin-embedded Human Stomach Tissue using IkBα(EA339)Rabbit?pAb diluted at 1:200.
Immunohistochemical analysis of paraffin-embedded Human Stomach Tissue using IkBα(EA339)Rabbit?pAb diluted at 1:200. -
 Western blot analysis of 1) Hela Cell Lysate, 2)PC12 Cell Lysate, 3) 3T3 Cell Lysate using IkB α (EA339)Rabbit pAb diluted at 1:1000.
Western blot analysis of 1) Hela Cell Lysate, 2)PC12 Cell Lysate, 3) 3T3 Cell Lysate using IkB α (EA339)Rabbit pAb diluted at 1:1000.
關(guān)閉
在線咨詢
Online consultation
-
在線咨詢
-
技術(shù)支持

關(guān)注微信公眾號




 下載說明 ①
下載說明 ①




